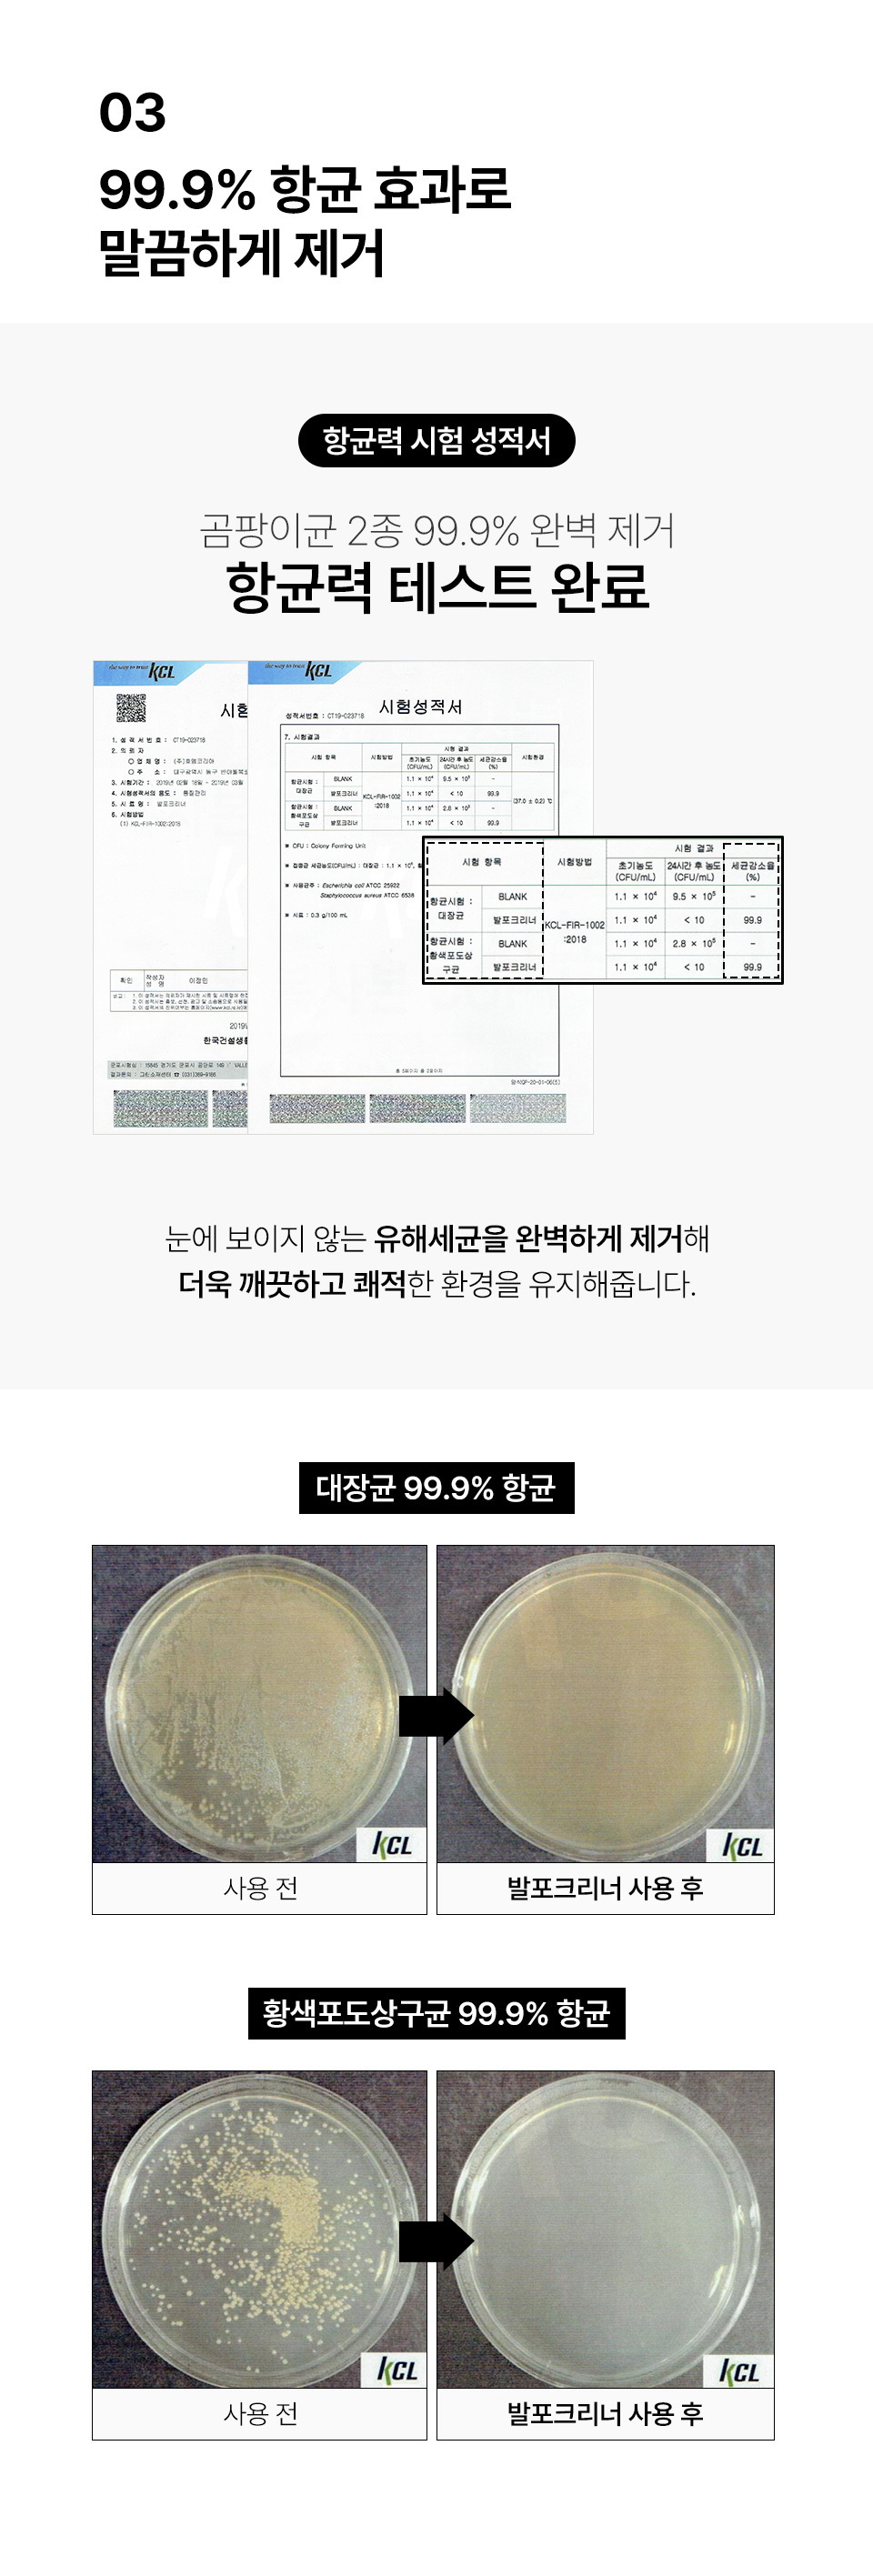

집코리아 발포크리너 350g 2개
19,370 원
배송정보
평균 1~2일 이내 배송
배송비
3,000원
(제주, 도서/산간 지역 추가비용)
적립금
상품 구매 금액의 3% (약 581원 적립)
총금액
19,370 원

배송/취소/반품 안내
배송 안내
- 배송 방법: 택배
- 배송비: 3,000원
- 배송 기간: 1~2일
- 배송 안내: 산간벽지나 도서지방은 별도의 추가금액을 지불하셔야 하는 경우가 있습니다.
취소 안내
취소 가능 시간 : 주문 완료 상태의 주문건은 취소하실 수 없습니다.
취소 환불 : 승인취소 완료까지는 최대 3일 ~ 5일 정도 소요됩니다.
반품 안내
반품이 가능한 경우
구매자 단순 변심은 상품 수령 후 7일 이내
표시/광고와 상이, 상품하자의 경우 상품 수령 후 3개월 이내 혹은 표시/광고와 다른 사실을 안 날로부터 30일 이내
반품이 불가능한 경우
반품 요청기간이 지난 경우
구매자의 책임 있는 사유로 상품 등이 멸실 또는 훼손된 경우 (단, 상품의 내용을 확인하기 위하여 포장등을 훼손한 경우는 제외)
세트상품 일부 사용, 구성품을 분실하였거나 취급 부주의로 인한 파손/고장/오염으로 재판매 불가한 경우
모니터 해상도의 차이로 인해 색상이나 이미지가 실제와 달라, 고객이 단순 변심으로 반품을 무료로 요청하는 경우
제조사의 사정 (신모델 출시 등) 및 부품 가격 변동 등에 의해 무료 반품으로 요청하는 경우
최근 본 상품
1 / 5




![[애경] [365일 갓성비 사은품] [최고급 라미네이팅 칼라코팅 박스] [도매꾹 생활1등기업] 참좋은선물](https://cdn1.domeggook.com/upload/item/2018/06/18/1529298775A7DD3ABE56A74778C4107C/1529298775A7DD3ABE56A74778C4107C_img_760?hash=d5c4b9ce182ccba2a6e1dbce1f8ae744)












